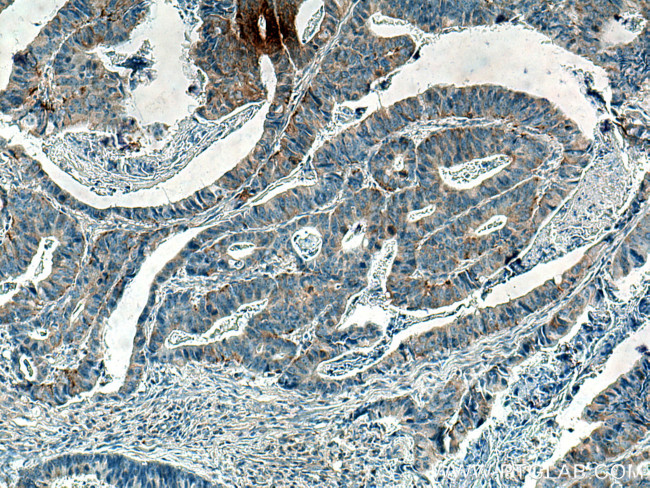
PKMYT1 Antibody in Immunohistochemistry (Paraffin) (IHC (P))

Search
Proteintech
PKMYT1 Monoclonal Antibody (1D12D3)
{{$productOrderCtrl.translations['antibody.pdp.commerceCard.promotion.promotions']}}
{{$productOrderCtrl.translations['antibody.pdp.commerceCard.promotion.viewpromo']}}
{{$productOrderCtrl.translations['antibody.pdp.commerceCard.promotion.promocode']}}: {{promo.promoCode}} {{promo.promoTitle}} {{promo.promoDescription}}. {{$productOrderCtrl.translations['antibody.pdp.commerceCard.promotion.learnmore']}}
产品信息
67806-1-IG
种属反应
宿主/亚型
分类
类型
克隆号
抗原
偶联物
形式
浓度
规格
纯化类型
保存液
内含物
保存条件
运输条件
产品详细信息
Aliquoting is unnecessary for -20°C storage.
靶标信息
PKMYT1 serine/threonine kinase is a member of a family of neural specific, zinc finger-containing DNA-binding proteins which binds to the promoter regions of proteolipid proteins of the central nervous system and plays a role in the developing nervous system. MYT1 of the oligodendrocyte lineage, along with a closely related CCHC zinc finger, is expressed in developing neurons in the mammalian central nervous system. The recombinant PKMYT1 fragments containing either the upstream 2 zinc fingers or the downstream 4 zinc fingers bound the same cis regulatory element in the PLP1 promoter in vitro and DNA binding required Zn2+, but not other divalent cations.
仅用于科研。不用于诊断过程。未经明确授权不得转售。
生物信息学
蛋白别名: Membrane-associated tyrosine- and threonine-specific cdc2-inhibitory kinase; membrane-associated tyrosine-and threonine-specific cdc2-inhibitory kinase; MYT1 kinase; protein phosphatase 1, regulatory subunit 126; unnamed protein product
基因别名: 6230424P17; AW209059; MYT1; PKMYT1; PPP1R126; RGD1305434
UniProt ID: (Human) Q99640, (Mouse) Q9ESG9
Entrez Gene ID: (Human) 9088, (Mouse) 268930, (Rat) 287101